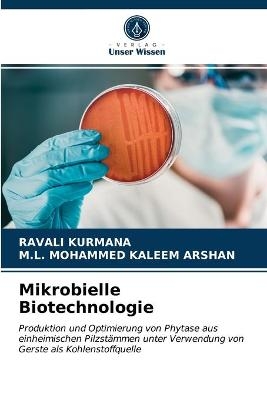
Mikrobielle Biotechnologie

Software / Digital Media
2021
|
Auflage:
6
|
Pearson Academic
ISBN: 9783967200829
- Titel nicht im Sortiment